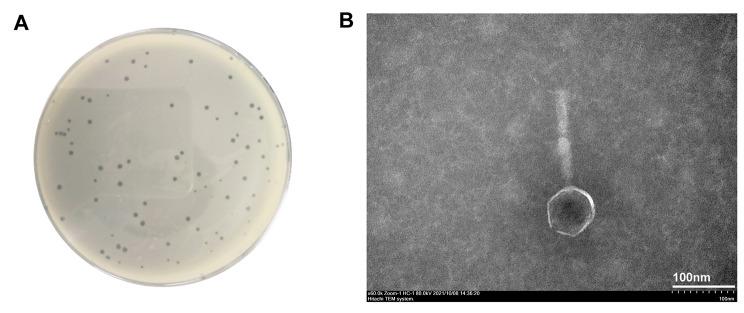

研究噬菌体 vB3530 和洗必泰联合作用对铜绿假单胞菌的灭活效果。
Study of Combined Effect of Bacteriophage vB3530 and Chlorhexidine on the Inactivation of Pseudomonas aeruginosa.
机构信息
Department of Clinical Laboratory, Key Laboratory of Clinical Laboratory Diagnosis and Translational Research of Zhejiang Province, the First Affiliated Hospital of Wenzhou Medical University, Wenzhou, 325000, China.
School of Basic Medical Sciences, Wenzhou Medical University, Wenzhou, 325000, Zhejiang Province, China.
出版信息
BMC Microbiol. 2023 Sep 13;23(1):256. doi: 10.1186/s12866-023-02976-w.
BACKGROUND
Chlorhexidine (CHG) is a disinfectant commonly used in hospitals. However, it has been reported that the excessive use of CHG can cause resistance in bacteria to this agent and even to other clinical antibiotics. Therefore, new methods are needed to alleviate the development of CHG tolerance and reduce its dosage. This study aimed to explore the synergistic effects of CHG in combination with bacteriophage against CHG-tolerant Pseudomonas aeruginosa (P. aeruginosa) and provide ideas for optimizing disinfection strategies in clinical environments as well as for the efficient use of disinfectants.
METHODS
The CHG-tolerant P. aeruginosa strains were isolated from the First Affiliated Hospital of Wenzhou Medical University in China. The bacteriophage vB3530 was isolated from the sewage inlet of the hospital, and its genome was sequenced. Time-killing curve was used to determine the antibacterial effects of vB3530 and chlorohexidine gluconate (CHG). The phage sensitivity to 16 CHG-tolerant P. aeruginosa strains and PAO1 strain was detected using plaque assay. The emergence rate of resistant bacterial strains was detected to determine the development of phage-resistant and CHG-tolerant strains. Finally, the disinfection effects of the disinfectant and phage combination on the surface of the medical devices were preliminarily evaluated.
RESULTS
The results showed that (1) CHG combined with bacteriophage vB3530 significantly inhibited the growth of CHG-resistant P. aeruginosa and reduced the bacterial colony forming units (CFUs) after 24 h. (2) The combination of CHG and bacteriophage inhibited the emergence of phage-resistant and CHG-tolerant strains. (3) The combination of CHG and bacteriophage significantly reduced the bacterial load on the surface of medical devices.
CONCLUSIONS
In this study, the combination of bacteriophage vB3530 and CHG presented a combined inactivation effect to CHG-tolerant P. aeruginosa and reduced the emergence of strains resistant to CHG and phage. This study demonstrated the potential of bacteriophage as adjuvants to traditional disinfectants. The use of bacteriophage in combination with commercial disinfectants might be a promising method for controlling the spread of bacteria in hospitals.
背景
洗必泰(CHG)是一种常用于医院的消毒剂。然而,据报道,CHG 的过度使用会导致细菌对此类药物产生耐药性,甚至对其他临床抗生素产生耐药性。因此,需要新的方法来减轻 CHG 耐药性的发展并减少其用量。本研究旨在探索 CHG 与噬菌体联合使用对 CHG 耐受铜绿假单胞菌(P. aeruginosa)的协同作用,为优化临床环境中的消毒策略以及高效使用消毒剂提供思路。
方法
从温州医科大学第一附属医院分离出 CHG 耐受铜绿假单胞菌菌株。从医院污水进口分离出噬菌体 vB3530,并对其基因组进行测序。采用时间杀伤曲线测定 vB3530 和葡萄糖酸洗必泰(CHG)的抗菌作用。采用噬菌斑法检测噬菌体对 16 株 CHG 耐受铜绿假单胞菌菌株和 PAO1 菌株的敏感性。检测耐药菌株的出现率,以确定噬菌体耐药和 CHG 耐受菌株的发展情况。最后,初步评价消毒剂和噬菌体联合对医疗器械表面的消毒效果。
结果
结果表明:(1)CHG 联合噬菌体 vB3530 显著抑制 CHG 耐药铜绿假单胞菌的生长,24 小时后降低细菌菌落形成单位(CFUs)。(2)CHG 与噬菌体联合抑制了噬菌体耐药和 CHG 耐受菌株的出现。(3)CHG 与噬菌体联合显著降低了医疗器械表面的细菌负荷。
结论
本研究中,噬菌体 vB3530 与 CHG 的联合使用对 CHG 耐受铜绿假单胞菌具有联合灭活作用,并降低了对 CHG 和噬菌体的耐药菌株的出现。本研究证明了噬菌体作为传统消毒剂佐剂的潜力。噬菌体与商业消毒剂联合使用可能是控制医院细菌传播的一种有前途的方法。